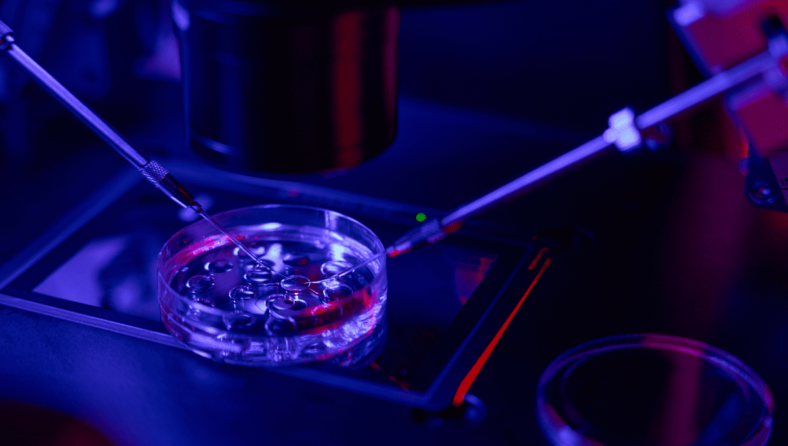
Diploma Course on Foundations of Cell & Gene Therapy

Email: info@irmsc.edu.pk Phone: (051) 3757635 Whatsapp: 0333-8434330
0.00
(0.00)
IRM Trainer
26 Courses • 2 Students
0.00
(0.00)
Biography
Bio data is emptyCourses
₨140,000.00
₨140,000.00
IRM Trainings
Medical College
397-Kortana, Opposite Gate 4 DHA Phase 2, G.T Road, Islamabad. Pakistan.
Phone: (051) 3757635
Whatsapp: 0333-8434330
Email: info@irmsc.edu.pk
Medical Hospital Facility:
IRM Hospital,
397-Kortana, Opposite Gate 4 DHA Phase 2, G.T Road, Islamabad. Pakistan.
Phone: (051) 3757635
WhatsApp: 0332-8434330
WhatsApp: 0333-8434330
Short Courses
- TENS & EMS
- Basic Kinesiology
- CPM & Traction Unit
- Basic Functional Anatomy
- Basic Exercise physiology
- Basic Physiotherapy treatment and techniques
- Therapeutic Ultrasound & Short-Wave Diathermy
- Autoclaves & Drying Ovens
- Centrifuges & Incubators
- Biosafety Cabinets
- Biosafety & Biosecurity & Bioethics
- Cell Analytics
- Therapeutic Ultrasound & Short-Wave Diathermy
- Cell Therapy Infusion Reactions